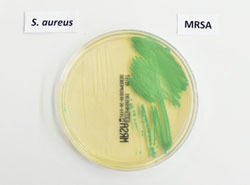
Bildquelle: Universit&auml;tsklinikum M&uuml;nster

Winterzeit ist Schnupfenzeit. Doch was sich da auf unseren Nasenschleimhäuten tummelt, sind nicht immer nur harmlose Schnupfenerreger. Wohl fühlen sich in unserer Nase nämlich auch antibiotikaresistente Bakterien: MRSA-Keime. Woher die Keime stammen können und warum besonders Menschen, die Kontakt zu Tieren haben, gefährdet sind, haben Wissenschaftler nun herausgefunden. (Newsletter 65 / Dezember 2013)
 Landluft ist gesund, sagt der Volksmund. Doch so pauschal stimmt das anscheinend nicht. Denn gerade Menschen, die in den ländlichen Regionen Deutschlands wohnen und in der Landwirtschaft direkten Kontakt zu Tieren haben, sind oftmals von ganz besonderen antibiotikaresistenten Bakterien befallen. Auf ihren Nasenschleimhäuten findet man ein Bakterium, das Methicillin-resistenter Staphylococcus aureus heißt, kurz MRSA. Der Erreger war lange Zeit nur als Krankenhauskeim beim Menschen bekannt. Jetzt haben Wissenschaftlerinnen und Wissenschaftler eine spezielle Unterform von MRSA nicht nur bei Tieren in der Landwirtschaft gefunden, vor allem bei Schweinen, Rindern und Geflügel, sondern auch bei Menschen, die Kontakt zu diesen Tieren haben. „Damit ist klar: Diese tierischen Erreger können tatsächlich vom Tier auf den Menschen übertragen werden. Sie haben es geschafft, die natürliche Wirtsgrenze zu überwinden. Und sie können auch beim Menschen schwerwiegende Infektionen auslösen“, sagt Dr. Robin Köck vom Universitätsklinikum Münster. Er leitet den vom Bundesministerium für Bildung und Forschung (BMBF) geförderten Forschungsverbund MedVet-Staph.
Landluft ist gesund, sagt der Volksmund. Doch so pauschal stimmt das anscheinend nicht. Denn gerade Menschen, die in den ländlichen Regionen Deutschlands wohnen und in der Landwirtschaft direkten Kontakt zu Tieren haben, sind oftmals von ganz besonderen antibiotikaresistenten Bakterien befallen. Auf ihren Nasenschleimhäuten findet man ein Bakterium, das Methicillin-resistenter Staphylococcus aureus heißt, kurz MRSA. Der Erreger war lange Zeit nur als Krankenhauskeim beim Menschen bekannt. Jetzt haben Wissenschaftlerinnen und Wissenschaftler eine spezielle Unterform von MRSA nicht nur bei Tieren in der Landwirtschaft gefunden, vor allem bei Schweinen, Rindern und Geflügel, sondern auch bei Menschen, die Kontakt zu diesen Tieren haben. „Damit ist klar: Diese tierischen Erreger können tatsächlich vom Tier auf den Menschen übertragen werden. Sie haben es geschafft, die natürliche Wirtsgrenze zu überwinden. Und sie können auch beim Menschen schwerwiegende Infektionen auslösen“, sagt Dr. Robin Köck vom Universitätsklinikum Münster. Er leitet den vom Bundesministerium für Bildung und Forschung (BMBF) geförderten Forschungsverbund MedVet-Staph.
Auf einer Petrischale können antibiotikaempfindliche Staphylococcus-aureus-Bakterien gut von resistenten MRSA unterschieden werden: Nur die antibiotikaresistenten Bakterien wachsen auf dem Nährboden, der Antibiotika enthält, und bilden Kolonien (rechts). Zoonosen: Sprung von Tier zu Mensch. Unter Zoonosen verstehen Wissenschaftlerinnen und Wissenschaftler Krankheiten, die zunächst nur beim Tier auftreten. Durch Veränderung ihres Erbmaterials schaffen sie jedoch den Sprung zum Menschen. Ein Beispiel ist die Vogelgrippe. Experten schätzen, dass mehr als 60 Prozent der 1.451 bekannten Erreger, die Infektionen beim Menschen auslösen, zwischen Tier und Mensch übertragen werden. Das Bundeskabinett hat schon 2006 eine Forschungsvereinbarung zu Krankheiten beschlossen, die von Tieren auf Menschen übertragbar sind. Beteiligt sind die Bundesministerien für Bildung und Forschung (BMBF), für Ernährung, Landwirtschaft und Verbraucherschutz (BMELV) und für Gesundheit (BMG). Durch verbesserte Zusammenarbeit von Veterinärmedizin und Humanmedizin soll die Übertragung von Erregern vom Tier auf den Menschen intensiver als bisher erforscht werden. Das BMBF fördert seit Juli 2007 13 interdisziplinäre Forschungsverbünde zu zoonotischen Infektionskrankheiten. 2008 ist die Nationale Forschungsplattform für Zoonosen eingerichtet worden. Sie wird ressortübergreifend von den drei genannten Ministerien getragen.
Auf einer Petrischale können antibiotikaempfindliche Staphylococcus-aureus-Bakterien gut von resistenten MRSA unterschieden werden: Nur die antibiotikaresistenten Bakterien wachsen auf dem Nährboden, der Antibiotika enthält, und bilden Kolonien (rechts). Zoonosen: Sprung von Tier zu Mensch. Unter Zoonosen verstehen Wissenschaftlerinnen und Wissenschaftler Krankheiten, die zunächst nur beim Tier auftreten. Durch Veränderung ihres Erbmaterials schaffen sie jedoch den Sprung zum Menschen. Ein Beispiel ist die Vogelgrippe. Experten schätzen, dass mehr als 60 Prozent der 1.451 bekannten Erreger, die Infektionen beim Menschen auslösen, zwischen Tier und Mensch übertragen werden. Das Bundeskabinett hat schon 2006 eine Forschungsvereinbarung zu Krankheiten beschlossen, die von Tieren auf Menschen übertragbar sind. Beteiligt sind die Bundesministerien für Bildung und Forschung (BMBF), für Ernährung, Landwirtschaft und Verbraucherschutz (BMELV) und für Gesundheit (BMG). Durch verbesserte Zusammenarbeit von Veterinärmedizin und Humanmedizin soll die Übertragung von Erregern vom Tier auf den Menschen intensiver als bisher erforscht werden. Das BMBF fördert seit Juli 2007 13 interdisziplinäre Forschungsverbünde zu zoonotischen Infektionskrankheiten. 2008 ist die Nationale Forschungsplattform für Zoonosen eingerichtet worden. Sie wird ressortübergreifend von den drei genannten Ministerien getragen.
MRSA: häufig und gefährlich
Kommen MRSA bei Tieren häufig vor? „Die Antwort lautet: Ja! Rund 30 Prozent der Rinder und 70 Prozent der Schweine sind MRSA-positiv.“ Auch bei Haustieren wie Hunden und Katzen wurden die resistenten Bakterien gefunden. Die Rate liegt jedoch unter 5 Prozent. Und damit nicht genug. In vielen Milch- und Fleischproben findet man ebenfalls MRSA. Allerdings schätzen Experten das Risiko als gering ein, sich über Lebensmittel mit MRSA zu infizieren. Staphylococcus aureus ist ein Bakterium, das zur normalen Bakterienflora des Menschen gehört. Bei etwa 20 bis 50 Prozent der gesunden Erwachsenen findet man das Bakterium auf den Schleimhäuten von Nase oder Rachen. Infektionen können dann entstehen, wenn es dem Bakterium gelingt, durch die Haut in die Tiefe zu dringen. Typische Infektionen beim Menschen sind dann eitrige Entzündungen der Haut, Entzündungen der Herzinnenhaut oder der Knochen. Diese Infektionen sind in der Regel gut mit Antibiotika behandelbar. Gefährlich wird es, wenn die Bakterien gegen die gängigen Wirkstoffe resistent sind. Diese Bakterien heißen dann MRSA. Die durch MRSA hervorgerufenen Infektionen sind zwar nicht gefährlicher als die durch antibiotikaempfindliche Staphylococcus aureus ausgelösten, jedoch schwerer behandelbar.

Wer in der Landwirtschaft tätig ist und täglich Kontakt zu Nutztieren hat, trägt oftmals antibiotikaresistente tierische MRSA-Bakterien in sich.
Übertragung zwischen Tier und Mensch?
Während antibiotikaresistente MRSA-Bakterien jahrzehntelang vor allem aus dem Krankenhaus bekannt waren, hat der Forschungsverbund nun herausgefunden, dass sie auch im Tierstall übertragen werden können. In einer groß angelegten Studie haben die Wissenschaftlerinnen und Wissenschaftler mehr als 14.000 MRSA-Proben aus Krankenhäusern und Arztpraxen untersucht. Die Ergebnisse: Etwa 2 Prozent der bei Patientinnen und Patienten in Deutschland gefundenen MRSA stammen ursprünglich vom Tier. Allerdings ist die Zahl regional sehr verschieden: In landwirtschaftlich geprägten Gegenden Deutschlands, wie im Münsterland, sind es deutlich mehr. Hier waren bis zu 29 Prozent aller Patientinnen und Patienten, die bei Aufnahme in ein Krankenhaus MRSA in der Nase trugen, von tierischen MRSA-Bakterien besiedelt. „Daraufhin haben wir die Landwirte im Münsterland genauer unter die Lupe genommen. Sie kommen tagtäglich mit Schweinen, Kühen oder Geflügel in Kontakt und sind deshalb eine mögliche Risikogruppe“, so Köck. Und tatsächlich: Drei von vier Landwirtinnen und Landwirten tragen den tierischen Erreger in der Nase. „Einen MRSA-Keim in der Nase zu tragen ist für sich genommen noch nicht gefährlich. Gefahr droht allerdings, wenn der Keim beispielsweise bei einer Operation in die Tiefe des Körpers gelangt. Dort löst er dann schwerste Infektionen aus, die mit den üblichen Antibiotika nicht behandelt werden können“, erklärt der Experte. In der Tat werden im Münsterland bis zu 10 Prozent aller gefährlichen MRSA-Infektionen in Krankenhäusern von tierischen Erregern verursacht. Betroffen sind davon nicht nur Personen mit direktem Tierkontakt, also etwa Landwirte oder Tierärzte, sondern beispielsweise auch ihre Familienmitglieder. „Wir vermuten deshalb, dass die Übertragung zwar hauptsächlich über den direkten Kontakt zu den Tieren erfolgt, die resistenten Bakterien aber durchaus auch indirekt übertragen werden können, wie beispielsweise im Haushalt oder Krankenhaus“, betont Köck.
Diagnose und Vorbeugung
Umso wichtiger ist es, die Erreger rechtzeitig zu diagnostizieren. Und noch besser: ihre Übertragung zu verhindern. Ein Problem in Sachen Diagnose ist, dass ein Teil der tierischen MRSA („mecC“) bislang durch die üblichen Laborverfahren nicht erkannt wird. Der MedStaphVet-Verbund entwickelt deshalb einen neuen Test, mit dem auch tierische MRSA diagnostiziert werden können. Bei der Prävention sind die Wissenschaftlerinnen und Wissenschaftler schon einen Schritt weiter. „Ergebnisse unseres Projektes werden derzeit in die Empfehlungen des Robert Koch-Instituts zum Hygienemanagement in Krankenhäusern eingearbeitet“, erläutert Köck. Etwa soll zukünftig berücksichtigt werden, dass bestimmte Personengruppen, zum Beispiel Landwirte mit Kontakt zu Nutztieren, ein hohes Risiko haben, von tierischen MRSA besiedelt zu sein. Für diese Personen sollen in Krankenhäusern besondere Empfehlungen gelten. „Wir wollen zum einen verhindern, dass sich die resistenten Keime im Krankenhaus weiterverbreiten. Zum anderen wollen wir die Betroffenen schützen“, so der Experte. Bei ihnen sollte der Keim beispielsweise vor einer anstehenden Operation behandelt werden, damit es erst gar nicht zu einer gefährlichen MRSA-Infektion kommen kann.
Ansprechpartner:
Dr. med. Robin Köck
Institut für Hygiene
Universitätsklinikum Münster
Robert-Koch-Str. 41
48149 Münster
Tel.: 0251 83-55348
Fax: 0251 83-55688
E-Mail: robin.koeck@ukmuenster.de